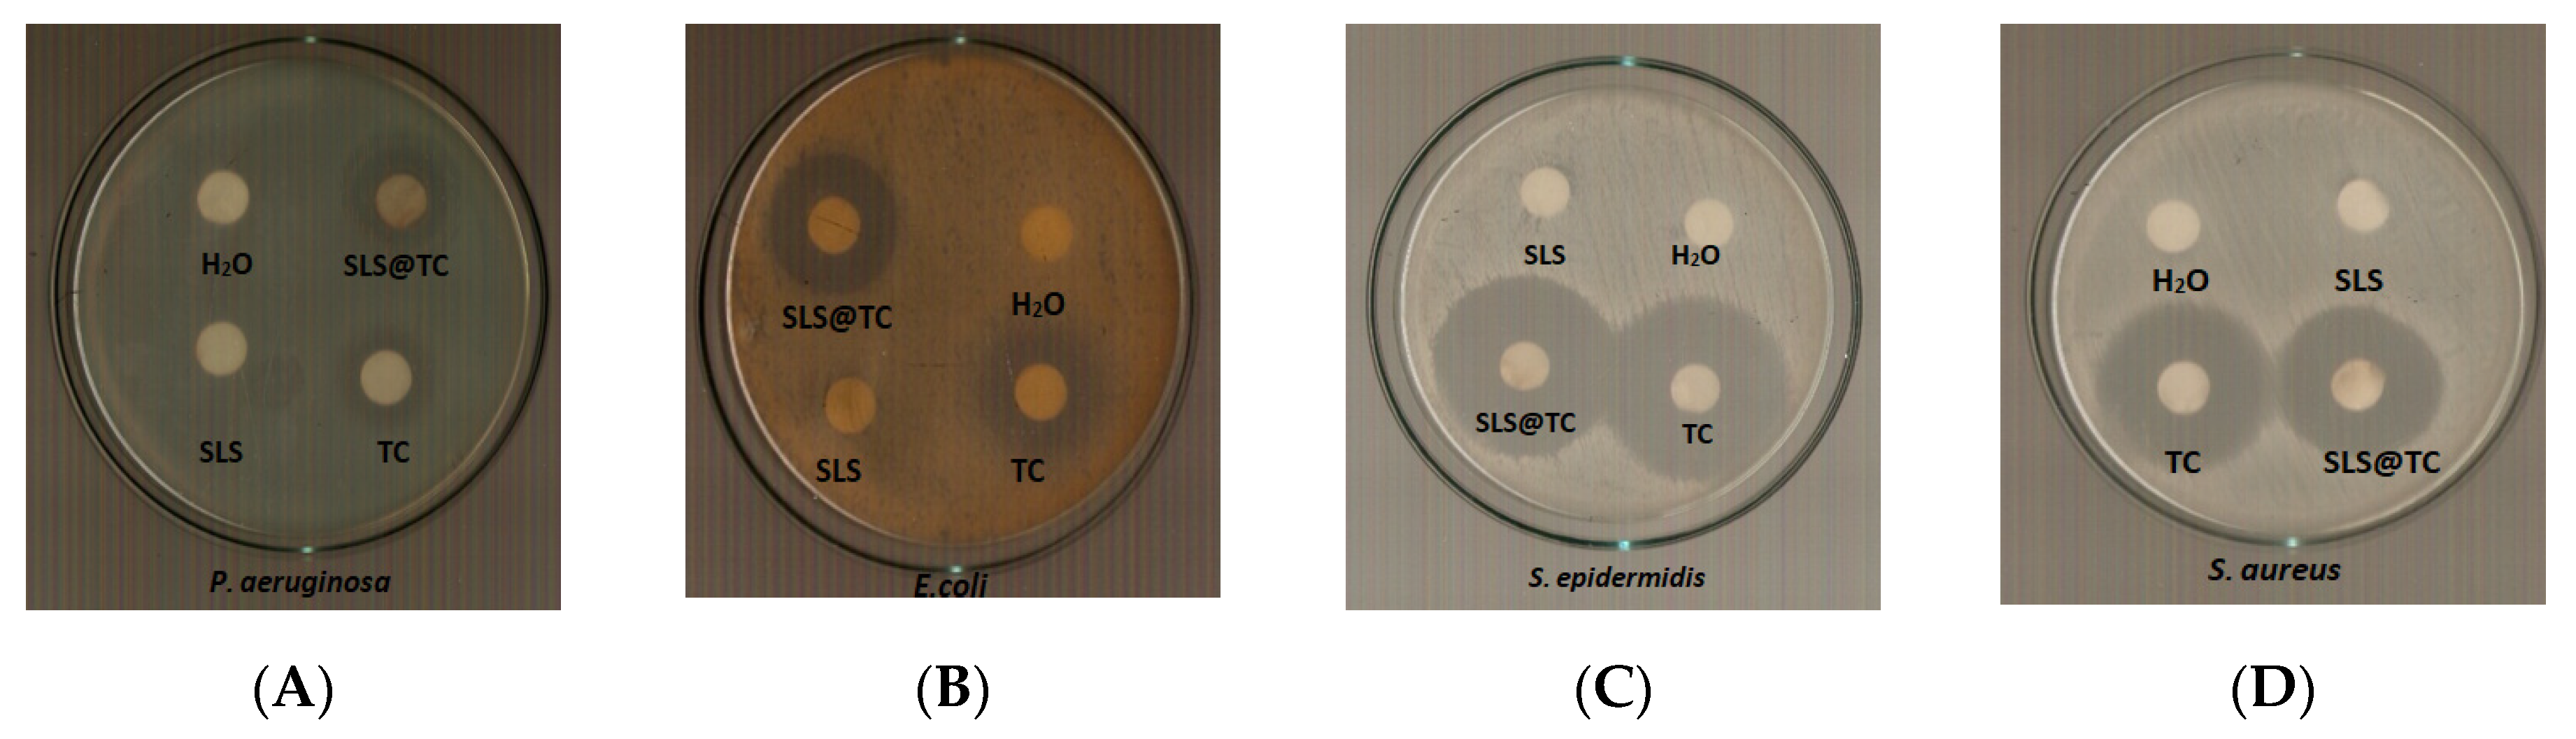
Antibiotics 09 00845 g012 Antibiotics 09 00845 g012
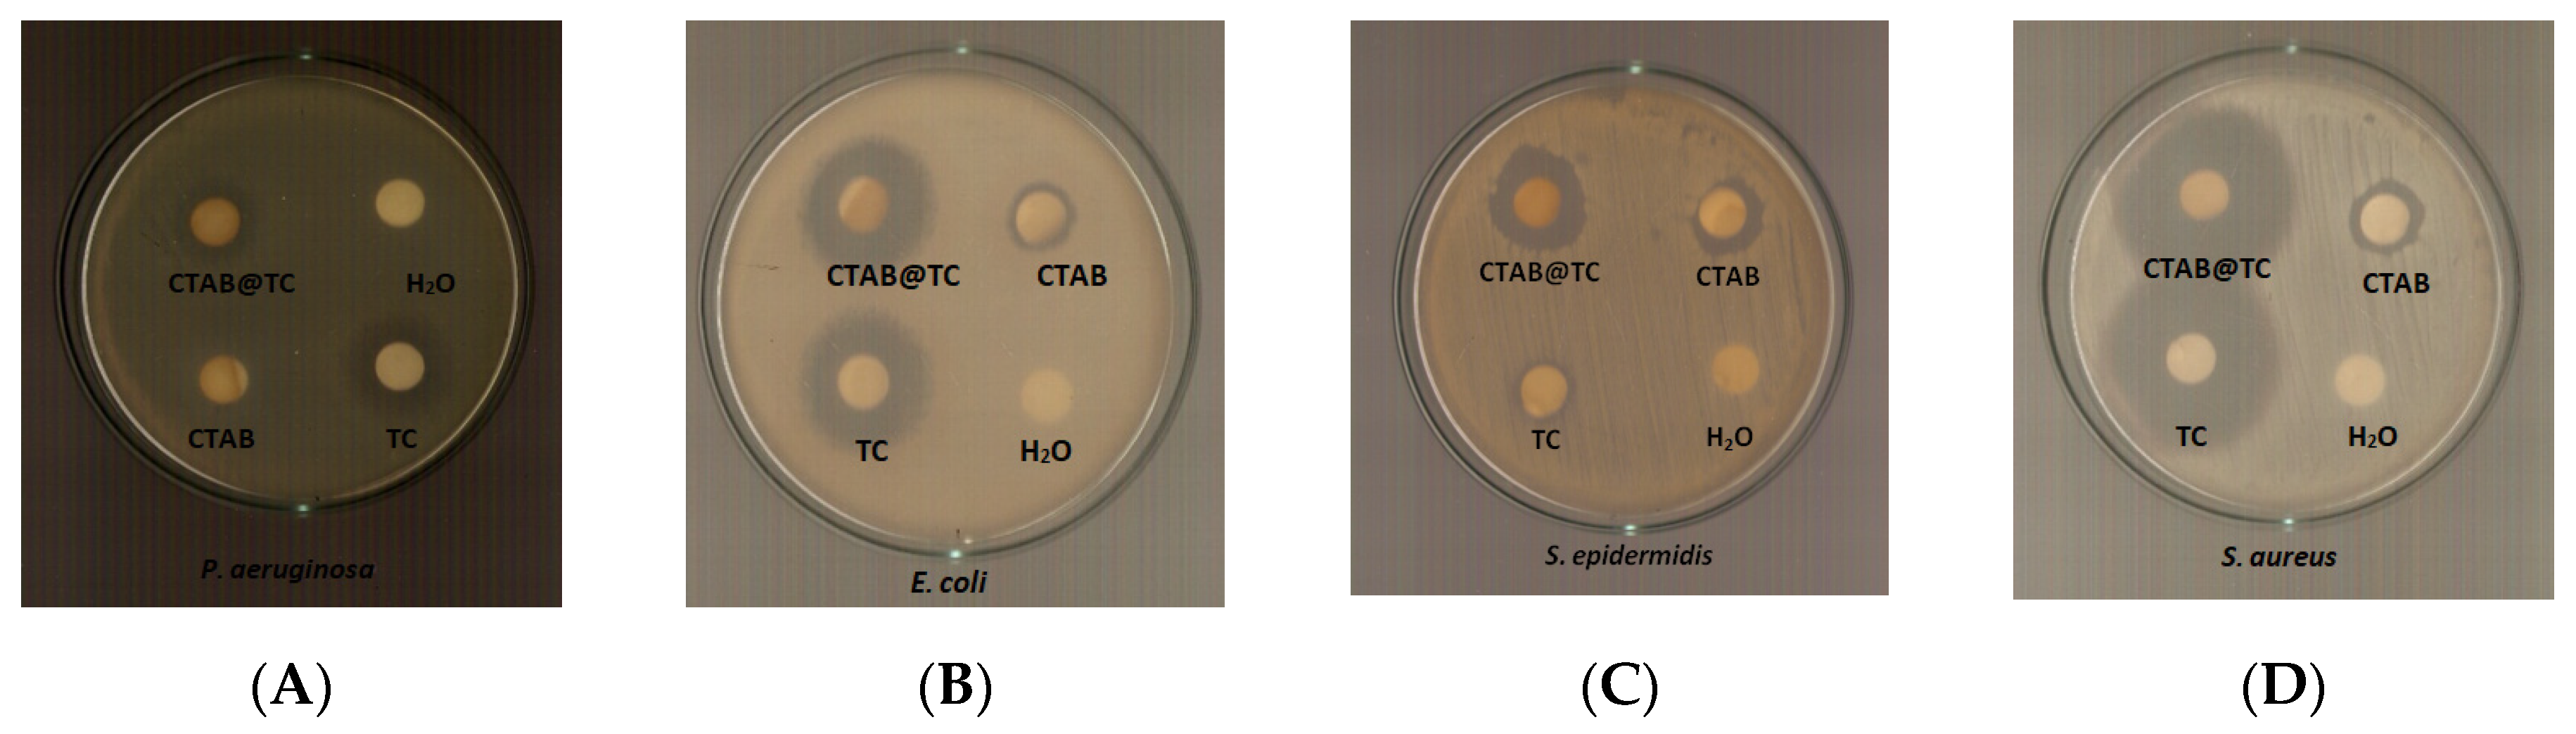
Antibiotics 09 00845 g013 Antibiotics 09 00845 g013
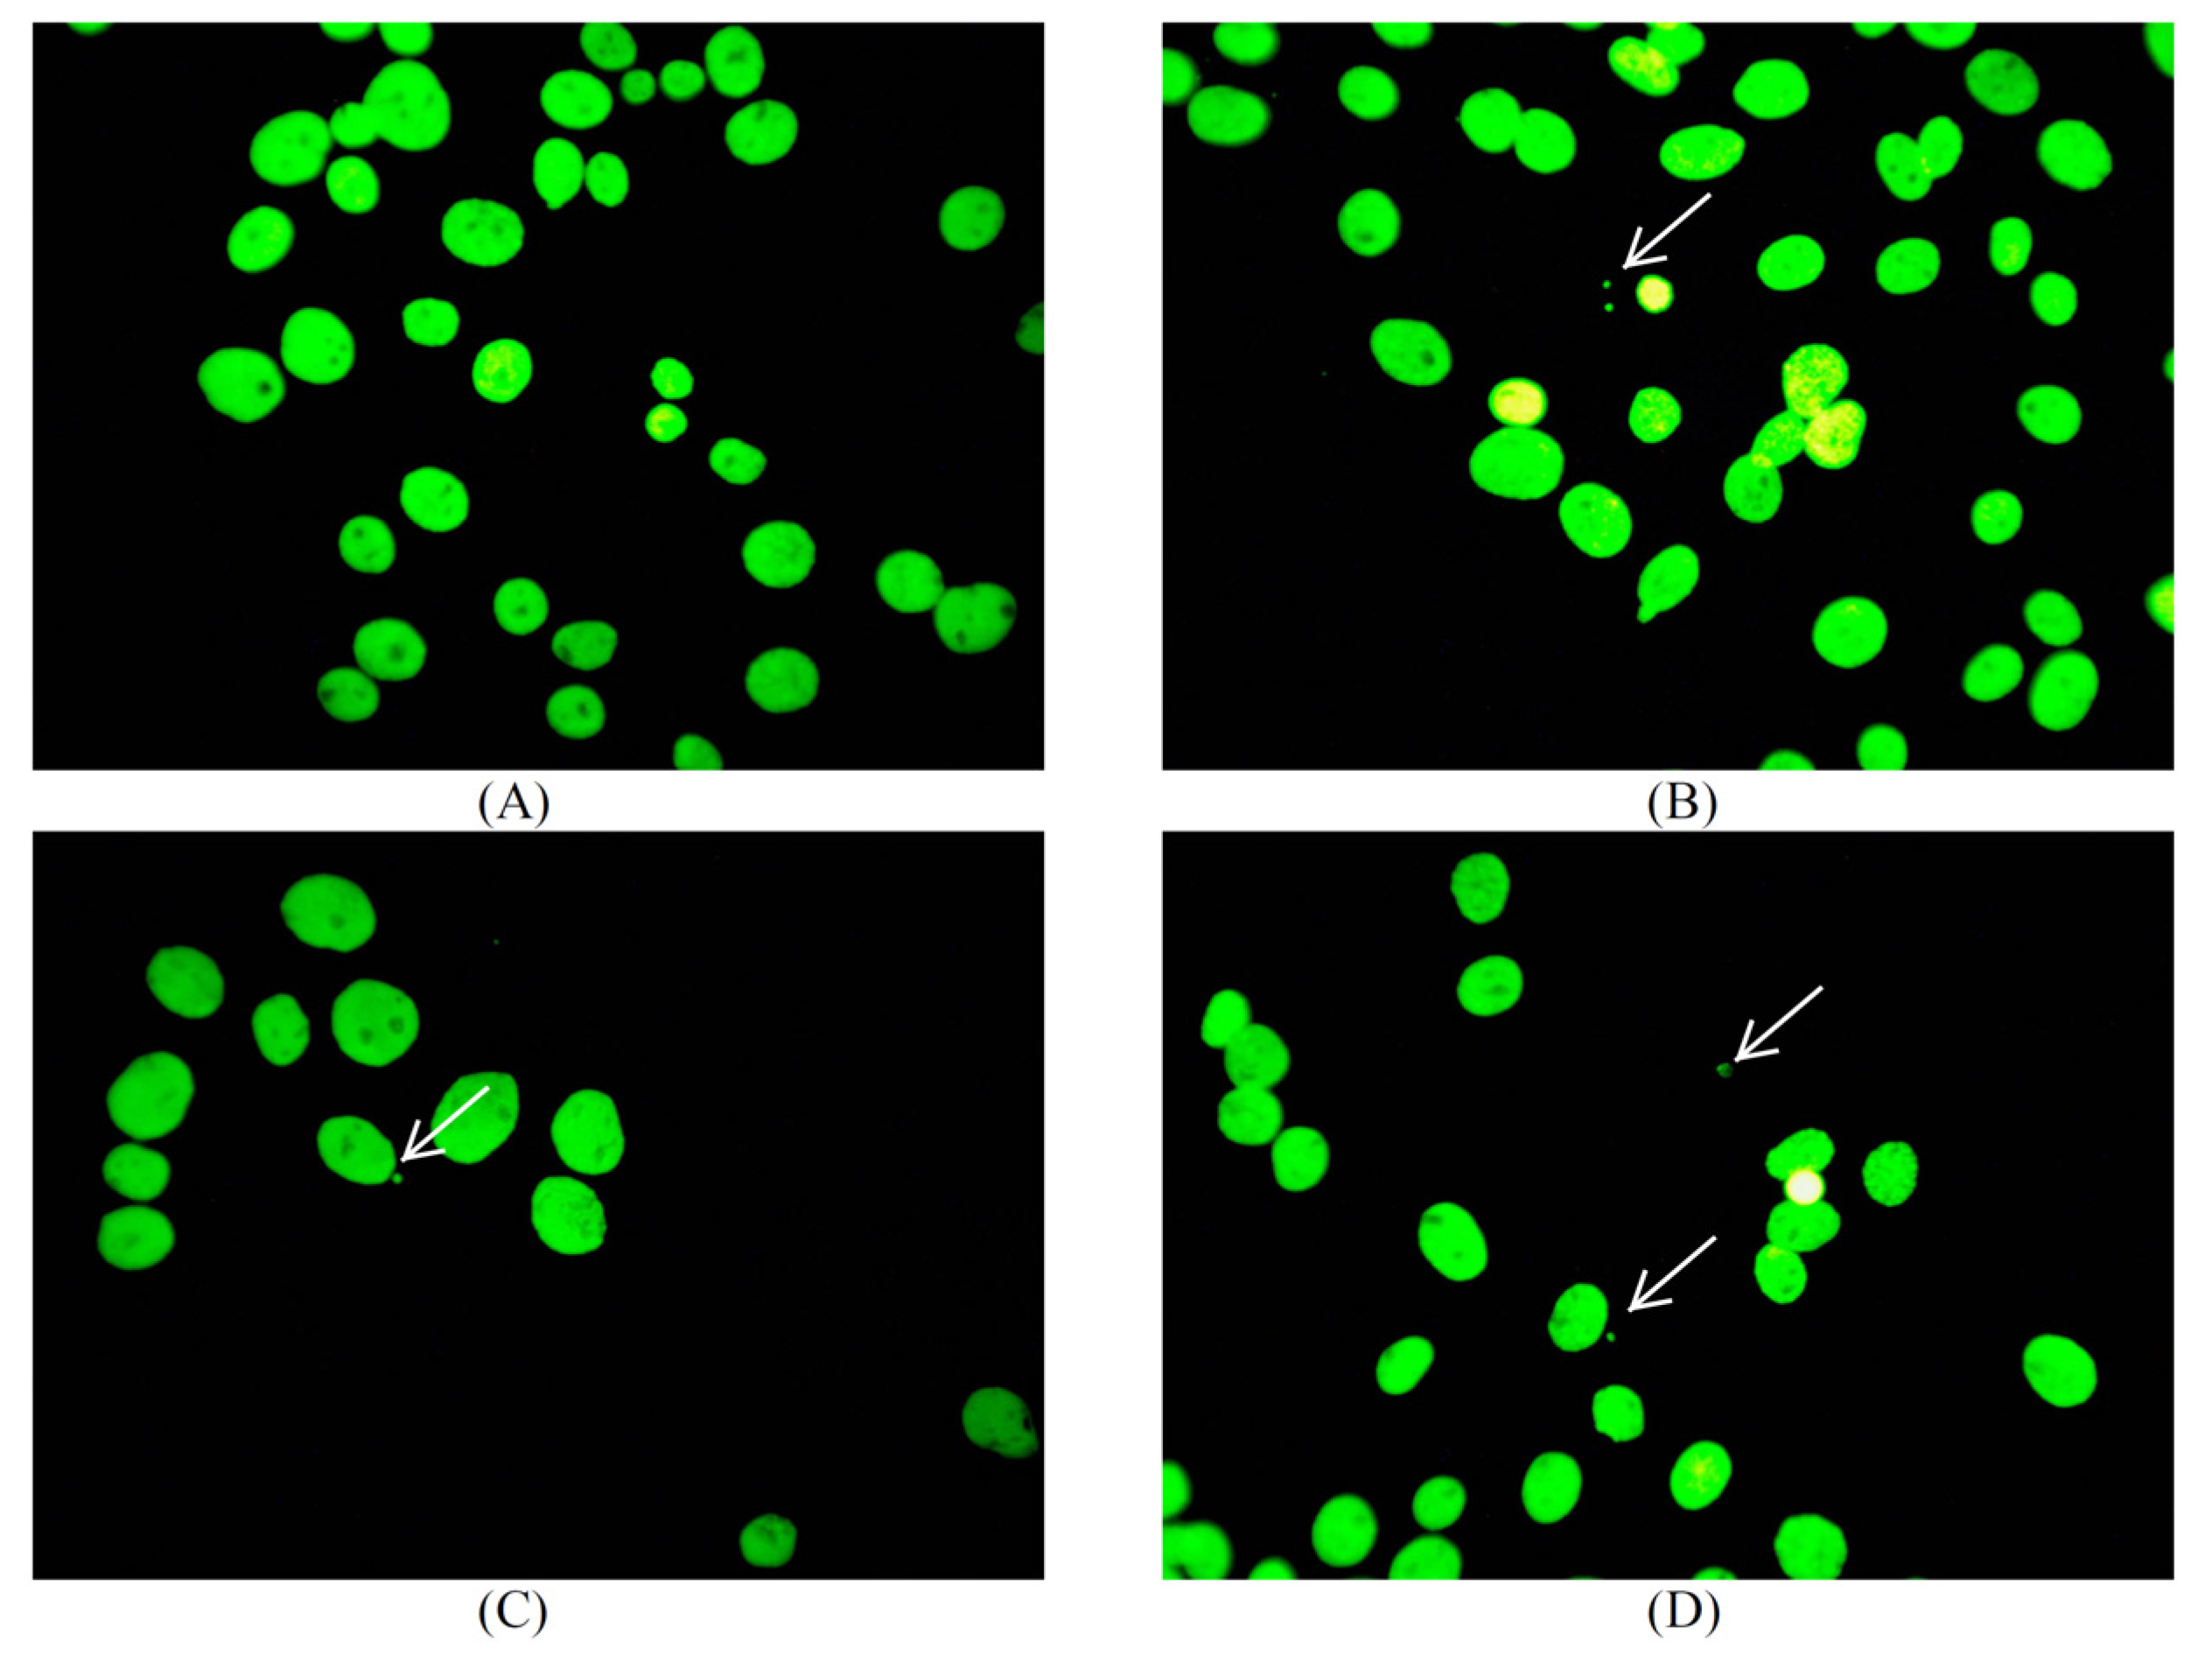
Antibiotics 09 00845 g014 Antibiotics 09 00845 g014

Tetracycline Water Soluble Formulations with Enhanced Antimicrobial Activity
Abstract
1. Introduction
2. Results
2.1. Preparation and Characterization of Micelle
Determination of Critical Micelle Concentration (CMC)
2.2. Solid State Studies
2.2.1. Thermo Gravimetric Analysis of SLS@TC and CTAB@TC
Thermal Decomposition
Differential Scanning Calorimetry (DSC)
Vibrational Spectroscopy
2.3. Solution Studies
2.3.1. UV/vis Study
2.3.2. 1H NMR Study
2.4. Probing Morphological Alterations by Means of Ultrasonically-Induced Transient Birefringence Experiments and ATR Spectroscopy
2.4.1. Transient Acoustically-Induced Birefringence Measurements
2.4.2. Attenuated Total Reflection Measurements
2.4.3. Vibrational Modes—Short-Range Structure
2.5. Antibacterial Studies
2.5.1. Effect of SLS@TC, CTAB@TC, TC, SLS, and CTAB on the Growth of Microbial Strains
2.5.2. Evaluation of the Minimum Bactericidal Concentration (MBC)
2.5.3. Determination of the Inhibition Zone (IZ) through the Agar Disk-Diffusion Method
2.5.4. Effect on Biofilm Formation by SLS@TC and CTAB@TC
2.5.5. Evaluation of In Vitro Toxicity
2.5.6. Evaluation of In Vitro Genotoxicity
2.6. In Vivo Toxicity Evaluation, by Brine Shrimp Artemia Salina
3. Conclusions
Experimental
Supplementary Materials
Author Contributions
Funding
Acknowledgments
Conflicts of Interest
References
- Grossman, T.H. Tetracycline Antibiotics and Resistance. Cold Spring Harb. Perspect. Med. 2016, 6, a025387. [Google Scholar] [CrossRef] [PubMed]
- Chopra, I.; Roberts, M. Tetracycline Antibiotics: Mode of Action, Applications, Molecular Biology, and Epidemiology of Bacterial Resistance. Microbiol. Mol. Biol. Rev. 2001, 5, 232–260. [Google Scholar] [CrossRef] [PubMed]
- Ralph, R.A. Tetracyclines and the treatment of corneal stromal ulceration: A review. Cornea 2000, 19, 274–277. [Google Scholar] [CrossRef] [PubMed]
- Pond, S.M.; Tozer, T.N. First-Pass Elimination Basic Concepts and Clinical Consequences. Clin. Pharm. 1984, 9, 1–25. [Google Scholar] [CrossRef] [PubMed]
- Varanda, F.; de Melo, M.J.P.; Caço, A.I.; Dohrn, R.; Makrydaki, F.A.; Voutsas, E.; Tassios, D.; Marrucho, I.M. Solubility of Antibiotics in Different Solvents. 1. Hydrochloride Forms of Tetracycline, Moxifloxacin, and Ciprofloxacin. Ind. Eng. Chem. Res. 2006, 45, 6368–6374. [Google Scholar] [CrossRef]
- Perneel, M.; D’hondt, L.; De Maeyer, K.; Adiobo, A.; Rabaey, K.; Höfte, M. Phenazines and biosurfactants interact in the biological control of soil-borne diseases caused by Pythium spp. Environ. Microbiol. 2008, 10, 778–788. [Google Scholar] [CrossRef] [PubMed]
- D’aes, J.; De Maeyer, K.; Pauwelyn, E.; Höfte, M. Biosurfactants in plant—Pseudomonas interactions and their importance to biocontrol. Environ. Microbiol. Rep. 2010, 2, 359–372. [Google Scholar] [CrossRef] [PubMed]
- Khedher, S.B.; Boukedi, H.; Dammak, M.; Kilani-Feki, O.; Sellami-Boudawara, T.; Abdelkefi-Mesrati, L.; Tounsi, S. Combinatorial effect of Bacillus amyloliquefaciens AG1 biosurfactant and Bacillus thuringiensis Vip3Aa16 toxin on Spodoptera littoralis larvae. J. Invertebr. Pathol. 2017, 144, 11–17. [Google Scholar] [CrossRef] [PubMed]
- Yin, X. Formulations combining ramoplanin and rhamnolipids for combating bacterial infection. U.S. Patent US20140294925A1, 2 October 2020. [Google Scholar]
- Bnyan, R.; Khan, I.; Ehtezazi, T.; Saleem, I.; Gordon, S.; O’Neill, F.; Roberts, M. Surfactant Effects on Lipid-Based Vesicles Properties. J. Pharm. Sci. 2018, 107, 1237–1246. [Google Scholar] [CrossRef] [PubMed]
- Bhadoriya, S.S.; Madoriya, N.; Shukla, K.; Parihar, M.S. Biosurfactants: A New Pharmaceutical Additive for Solubility Enhancement and Pharmaceutical Development. Biochem. Pharm. Open Access 2013, 2, 2–6. [Google Scholar] [CrossRef]
- Pham, T.-N.; Loupias, P.; Dassonville-Klimpt, A.; Sonnet, P. Drug delivery systems designed to overcome antimicrobial resistance. Med. Res. Rev. 2019, 39, 2343–2396. [Google Scholar] [CrossRef] [PubMed]
- Polubesova, T.; Zadaka, D.; Groisman, L.; Nira, S. Water remediation by micelle-clay system: Case study for tetracycline and sulfonamide antibiotics. Water Res. 2006, 40, 2369–2374. [Google Scholar] [CrossRef] [PubMed]
- Rashid, M.A.; Naz, T.; Abbas, M.; Nazir, S.; Younas, N.; Majeed, S.; Qureshi, N.; Akhtard, M.N. Chloramphenicol Loaded Microemulsions: Development, Characterization and Stability. Colloids Interface Sci. Commun. 2019, 28, 41–48. [Google Scholar] [CrossRef]
- Hage-Hülsmann, J.; Grünberger, A.; Thies, S.; Santiago-Schübel, B.; Klein, A.S.; Pietruszka, J.; Binder, D.; Hilgers, F.; Domröse, A.; Drepper, T.; et al. Natural biocide cocktails: Combinatorial antibiotic effects of prodigiosin and biosurfactants. PLoS ONE 2018, 13, e0200940. [Google Scholar] [CrossRef]
- Azari, A.A.; Barney, N.P. Conjunctivitis: A systematic review of diagnosis and treatment. JAMA 2013, 310, 1721–1729. [Google Scholar] [CrossRef]
- Bertino, J.S. Impact of antibiotic resistance in the management of ocular infections: The role of current and future antibiotics. Clin. Ophthalmol. 2009, 3, 507–521. [Google Scholar] [CrossRef]
- Lobanovska, M.; Pilla, G. Penicillin’s Discovery and Antibiotic Resistance: Lessons for the Future? Yale J. Biol. Med. 2017, 90, 135–145. [Google Scholar]
- Mingeot-Leclercq, M.-P.; Tulkens, P.M. Aminoglycosides: Nephrotoxicity. Antimicrob. Agents Chemother. 1999, 43, 1003–1012. [Google Scholar] [CrossRef]
- Ezelarab, H.A.A.; Abbas, S.H.; Hassan, H.A.; Abuo-Rahma, G.; El-Din, A. Recent updates of fluoroquinolones as antibacterial agents. Arch. Pharm. (Weinheim) 2018, 351, e1800141. [Google Scholar] [CrossRef]
- Kyros, L.; Banti, C.N.; Kourkoumelis, N.; Kubicki, M.; Sainis, I.; Hadjikakou, S.K. Synthesis, characterization, and binding properties towards CT-DNA and lipoxygenase of mixed-ligand silver(I) complexes with 2-mercaptothiazole and its derivatives and triphenylphosphine. J. Biol. Inorg. Chem. 2014, 19, 449–464. [Google Scholar] [CrossRef]
- Sainis, I.; Banti, C.N.; Owczarzak, A.M.; Kyros, L.; Kourkoumelis, N.; Kubicki, M.; Hadjikakou, S.K. New antibacterial, non-genotoxic materials, derived from the functionalization of the anti-thyroid drug methimazole with silver ions. J. Inorg. Biochem. 2016, 160, 114–124. [Google Scholar] [CrossRef] [PubMed]
- Papadimitriou, A.; Ketikidis, I.; Stathopoulou, M.K.; Banti, C.N.; Papachristodoulou, C.; Zoumpoulakis, L.; Agathopoulos, S.; Vagenas, G.V.; Hadjikakou, S.K. Innovative material containing the natural product curcumin, with enhanced antimicrobial properties for active packaging. Mater. Sci. Eng. C 2018, 84, 118–122. [Google Scholar] [CrossRef] [PubMed]
- Milionis, I.; Banti, C.N.; Sainis, I.; Raptopoulou, C.P.; Psycharis, V.; Kourkoumelis, N.; Hadjikakou, S.K. Silver ciprofloxacin (CIPAG): A successful combination of antibiotics in inorganic-organic hybrid for the development of novel formulations based on chemically modified commercially available antibiotics. J. Biol. Inorg. Chem. 2018, 23, 705–723. [Google Scholar] [CrossRef] [PubMed]
- Stathopoulou, M.-E.K.; Banti, C.N.; Kourkoumelis, N.; Hatzidimitriou, A.G.; Kalampounias, A.G.; Hadjikakou, S.K. Silver complex of salicylic acid and its hydrogel-cream in wound healing chemotherapy. J. Inorg. Biochem. 2018, 181, 41–55. [Google Scholar] [CrossRef] [PubMed]
- Chrysouli, M.P.; Banti, C.N.; Milionis, I.; Koumasi, D.; Raptopoulou, C.P.; Psycharis, V.; Sainis, I.; Hadjikakou, S.K. A water-soluble silver (I) formulation as an effective disinfectant of contact lenses cases. Mater. Sci. Eng. C 2018, 93, 902–910. [Google Scholar] [CrossRef] [PubMed]
- Karetsi, V.A.; Banti, C.N.; Kourkoumelis, N.; Papachristodoulou, C.; Stalikas, C.D.; Raptopoulou, C.P.; Psycharis, V.; Zoumpoulakis, P.; Mavromoustakos, T.; Sainis, I.; et al. An Efficient Disinfectant, Composite Material {SLS@[Zn3(CitH)2]} as Ingredient for Development of Sterilized and Non Infectious Contact Lens. Antibiotics 2019, 8, 213. [Google Scholar] [CrossRef] [PubMed]
- Ketikidis, I.; Banti, C.N.; Kourkoumelis, N.; Tsiafoulis, C.G.; Papachristodoulou, C.; Kalampounias, A.G.; Hadjikakou, S.K. Conjugation of Penicillin-G with Silver(I) Ions Expands Its Antimicrobial Activity against Gram Negative Bacteria. Antibiotics 2020, 9, 25. [Google Scholar] [CrossRef] [PubMed]
- Rossos, A.K.; Banti, C.N.; Kalampounias, A.; Papachristodoulou, C.; Kordatos, K.; Zoumpoulakis, P.; Mavromoustakos, T.; Kourkoumelis, N.; Hadjikakou, S.K. pHEMA@AGMNA-1: A novel material for the development of antibacterial contact lens. Mater. Sci. Eng. C 2020, 111, 110770. [Google Scholar] [CrossRef] [PubMed]
- Bhardwaj, V.; Bhardwaj, T.; Sharma, K.; Gupta, A.; Chauhan, S.; Cameotra, S.S.; Sharma, S.; Guptad, R.; Sharma, P. Drug-surfactant interaction: Thermo-acoustic investigation of sodium dodecyl sulfate and antimicrobial drug (levofloxacin) for potential pharmaceutical application. RSC Adv. 2014, 4, 24935–24943. [Google Scholar] [CrossRef]
- Mondal, R.; Ghosh, N.; Mukherjee, S. Enhanced Binding of Phenosafranin to Triblock Copolymer F127 Induced by Sodium Dodecyl Sulfate: A Mixed Micellar System as an Efficient Drug Delivery Vehicle. J. Phys. Chem. B 2016, 120, 2968–2976. [Google Scholar] [CrossRef] [PubMed]
- Shen, J.; Wang, Y.; Fana, P.; Jiang, L.; Zhuang, W.; Han, Y.; Zhang, H. Self-assembled vesicles formed by C18 unsaturated fatty acids and sodium dodecyl sulfate as a drug delivery system. Colloids Surf. A Phys. Eng. Asp. 2019, 568, 66–74. [Google Scholar] [CrossRef]
- Xia, D.; Yu, H.; Tao, J.; Zeng, J.; Zhu, Q.; Zhu, C.; Gan, Y. Supersaturated polymeric micelles for oral cyclosporine A delivery: The role of Soluplus–sodium dodecyl sulfate complex. Colloids Surf. B 2016, 141, 301–310. [Google Scholar] [CrossRef] [PubMed]
- Li, W.; Luo, T.; Yang, Y.; Tan, X.; Liu, L. Formation of Controllable Hydrophilic/Hydrophobic Drug Delivery Systems by Electrospinning of Vesicles. Langmuir 2015, 31, 5141–5146. [Google Scholar] [CrossRef] [PubMed]
- Laemmli, U.K. Cleavage of structural proteins during the assembly of the head of bacteriophage T4. Nature 1970, 227, 680–685. [Google Scholar] [CrossRef] [PubMed]
- Bondi, C.A.M.; Marks, J.L.; Wroblewski, L.B.; Raatikainen, H.S.; Lenox, S.R.; Gebhardt, K.E. Human and Environmental Toxicity of Sodium Lauryl Sulfate (SLS): Evidence for Safe Use in Household Cleaning Products. Environ. Health Insights 2015, 9, 27–32. [Google Scholar] [CrossRef]
- Wang, L.; Chen, H.; He, Y.-E.; Li, Y.; Li, M.; Li, X. Long chain olefin hydroformylation in biphasic catalytic system—How the reaction is accelerated. Appl. Catal. A 2003, 242, 85–88. [Google Scholar] [CrossRef]
- Casy, A.F.; Yasin, A. The identification and stereochemical study of tetracycline antibiotics by 1H nuclear magnetic resonance spectroscopy. J. Pharm. Biomed. Anal. 1983, 1, 281–292. [Google Scholar] [CrossRef]
- Stogiannidis, G.; Tsigoias, S.; Kaziannis, S.; Kalampounias, A.G. Stationary and transient acoustically induced birefringence of methyl acetate molecules dissolved in ethanol. Chem. Pap. 2020, 74, 2059–2067. [Google Scholar] [CrossRef]
- Degiorgio, V.; Piazza, R.; Mantegazza, F.; Bellini, T. Stretched-exponential relaxation of electric birefringence in complex liquids. J. Phys. Condens. Matter 1990, 2, SA69. [Google Scholar] [CrossRef]
- Pochylski, M.; Lombardo, D.; Calandra, P. Optical Birefringence Growth Driven by Magnetic Field in Liquids: The Case of Dibutyl Phosphate/Propylamine System. Appl. Sci. 2020, 10, 164. [Google Scholar] [CrossRef]
- Benoit, H. Study of the Kerr effect by dilute solutions of rigid macromolecules. Ann. Phys. 1951, 12, 6. [Google Scholar]
- Frisch, M.J.; Trucks, G.W.; Schlegel, H.B.; Scuseria, G.E.; Robb, M.A.; Cheeseman, J.R.; Scalmani, G.; Barone, V.; Mennucci, B.; Petersson, G.A.; et al. Gaussian 09 Software; Gaussian, Inc.: Wallingford, CT, USA, 2009. [Google Scholar]
- Watson, R.; Jennings, B. Polydisperse size data from single electric birefrignence transients. Powder Technol. 1992, 72, 63–69. [Google Scholar] [CrossRef]
- Skripkin, M.Y.; Lindqvist-Reis, P.; Abbasi, A.; Mink, J.; Perssone, I.; Sandström, M. Vibrational spectroscopic force field studies of dimethyl sulfoxide and hexakis(dimethyl sulfoxide)scandium(iii) iodide, and crystal and solution structure of the hexakis(dimethyl sulfoxide)scandium(iii) ion. Dalton Trans. 2004, 23, 4038–4049. [Google Scholar] [CrossRef] [PubMed]
- Fawcett, W.R.; Kloss, A.A. Attenuated total reflection fourier-transform IR spectroscopic study of dimethyl sulfoxide self-association in acetonitrile solutions. J. Phys. Chem. 1996, 92, 3333–3337. [Google Scholar] [CrossRef]
- Horrocks, W.D.; Cotton, F.A. Infrared and Raman spectra and normal co-ordinate analysis of dimethyl sulfoxide and dimethyl sulfoxide-d6Spectrochim. Spectrochim. Acta 1961, 17, 134. [Google Scholar] [CrossRef]
- Dobson, K.D.; Roddick-Lanzilotta, A.D.; McQuillan, A.J. An in situ infrared spectroscopic investigation of adsorption of sodium dodecyl sulfate and of cetyltrimethylammonium bromide surfactants to TiO2, ZrO2, Al2O3, and Ta2O4 Particle Films from Aqueous Solutions. Vib. Spectrosc. 2000, 24, 287–295. [Google Scholar] [CrossRef]
- Sperline, R.P.; Song, Y.; Freiser, H. Fourier transform infrared attenuated total reflection spectroscopy linear dichroism study of sodium dodecyl sulfate adsorption at the alumina/water interface using alumina-coated optics. Langmuir 1992, 8, 2183. [Google Scholar] [CrossRef]
- Hug, S.J. In Situ Fourier Transform Infrared Measurements of Sulfate Adsorption on Hematite in Aqueous Solutions. J. Colloid Interface Sci. 1997, 188, 415–422. [Google Scholar] [CrossRef]
- Nakamoto, K. Infrared and Raman Spectra of Inorganic and Coordination Compounds; Wiley: New York, NY, USA, 1986. [Google Scholar]
- Li, H.; Tripp, C.P. Use of Infrared Bands of the Surfactant Headgroup to Identify Mixed Surfactant Structures Adsorbed on Titania. J. Phys. Chem. B 2004, 108, 18318–18326. [Google Scholar] [CrossRef]
- Kumaran, D.; Taha, M.; Yi, Q.L.; Ramirez-Arcos, S.; Diallo, J.-S.; Carli, A.; Abdelbary, H. Does Treatment Order Matter? Investigating the Ability of Bacteriophage to Augment Antibiotic Activity against Staphylococcus aureus Biofilms. Front. Microbiol. 2018, 9, 127. [Google Scholar] [CrossRef]
- Banti, C.N.; Hadjikakou, S.K. Evaluation of Genotoxicity by Micronucleus Assay in vitro and by Allium cepa Test in vivo. Bio-Protocol 2019, 9, e3311. [Google Scholar] [CrossRef]
- Kostenko, V.; Ceri, H.; Martinuzzi, R.J. Increased tolerance of Staphylococcus aureus to vancomycin in Viscous media. FEMS Immunol. Med. Microbiol. 2007, 51, 277–288. [Google Scholar] [CrossRef] [PubMed]

| Td | C3ν | C2ν | Cs | C1 |
|---|---|---|---|---|
ν1(Α1)![]() | ν1(Α1)![]() | ν1(Α1)![]() | ν1(Α’)![]() | ν1(Α) |
ν2(Ε)![]() | ν2(Ε)![]() | ν2a(Α1)![]() ν2b(Α2) ![]() | ν2a(Α’)![]() ν2b(Α”) ![]() | ν2a(Α) ν2b(Α) |
ν3(F2)![]() | ν3a(Α1)![]() ν3b(E) ![]() | ν3a(Α1)![]() ν3b(B1) ![]() ν3c(B2) ![]() | ν3a(Α’)![]() ν3b(Α’) ![]() ν3c(A”) ![]() | ν3a(Α) ν3b(Α) ν3c(A) |
ν4(F2)![]() | ν4a(Α1)![]() ν3b(E) ![]() | ν4a(Α1)![]() ν4b(B1) ![]() ν4(B2) ![]() | ν4a(Α’)![]() ν4b(Α’) ![]() ν4c(A”) ![]() | ν4a(Α) ν4b(Α) ν4c(A) |
| Sample | P. aeruginosa | E. coli | S. epidermidis | S. aureus | Ref. |
|---|---|---|---|---|---|
| MIC (μΜ) | |||||
| SLS@TC | 27.20 ± 1.60 | 4.07 ± 0.30 | 6.22 ± 0.80 | 3.70 ± 0.82 | * |
| CTAB@TC | 5.80 ± 0.41 | 0.13 ± 0.002 | 0.07 ± 0.01 | 0.15 ± 0.04 | * |
| TC | 28.60 ± 4.90 | 5.60 ± 1.33 | 37.80 ± 14.06 | 1.32 ± 0.34 | * |
| SLS | >250 | 39.80 ± 0.60 | 49.70 ± 0.40 | 42.90 ± 6.20 | [27] |
| CTAB | >300 | 5.08 ± 1.11 | 0.36 ± 0.09 | 1.95 ± 0.36 | |
| MBC (μΜ) | |||||
| SLS@TC | 87.10 ± 6.90 | 116.6 ± 20.60 | 12.00 ± 4.00 | 9.10 ± 1.10 | * |
| CTAB@TC | 95.0 ± 5.70 | 12.0 ± 4.50 | 1.30 ± 0.40 | 0.50 ± 0.10 | * |
| TC | 92.0 ± 18.00 | 150.0 ± 25.30 | 171.40 ± 29.10 | 10.0 ± 0.0 | * |
| SLS | >250 | >250 | 100 | 60 | [27] |
| CTAB | >300 | 150.0 ± 40.0 | 5.30 ± 0.70 | 10.0 ± 0.0 | |
| MBC/MIC | |||||
| SLS@TC | 3.19 | 28.64 | 1.92 | 2.45 | * |
| CTAB@TC | 16.26 | 92.30 | 18.57 | 3.33 | * |
| TC | 3.21 | 26.60 | 4.53 | 7.57 | * |
| SLS | ND | ND | 2.01 | 1.39 | [27] |
| CTAB | 29.52 | 14.70 | 5.12 | ||
| IZ (mm) | |||||
| SLS@TC | 23.8 ± 1.2 | 29.3 ± 3.4 | 31.8 ± 3.1 | 30.5 ± 1.0 | * |
| CTAB@TC | 13.7 ± 0.3 | 22.7 ± 0.9 | 20.0 ± 1.5 | 34.0 ± 2.0 | * |
| TC | 15.2 ± 1.4 | 22.5 ± 0.6 | 11.8 ± 0.5 | 34.3 ± 1.8 | * |
| SLS | ND | ND | ND | ND | [27] |
| CTAB | ND | 12.0 ± 0.6 | 14.3 ± 1.3 | 14.3 ± 0.7 | * |
| BEC (μΜ) | |||||
| SLS@TC | 557 ± 111 | - | - | 1913 ± 380 | * |
| CTAB@TC | 1875 ± 614 | - | - | 983 ± 204 | * |
| TC | 427 ± 84 | - | - | >2304 | [53] |
| IC50 (μΜ) HCEC cells | |||||
| SLS@TC | 14.1 ± 0.40 | * | |||
| CTAB@TC | 0.09 ± 0.01 | * | |||
| TC | >60 | * | |||
| SLS | >60 | * | |||
| CTAB | 3.7 ± 0.10 | * | |||
| Micelle | MICmin | MICmax | 2 × MICmax | 3 × MICmax |
|---|---|---|---|---|
| SLS@TC | 78.6 ± 15.2 | 79.5 ± 15.0 | 50.0 ± 14.0 | 59.1 ± 8.9 |
| CTAB@TC | 93.8 ± 12.2 | 62.5 ± 24.5 | 75.0 ± 49.0 | 71.7 ± 22.9 |
Publisher’s Note: MDPI stays neutral with regard to jurisdictional claims in published maps and institutional affiliations. |
© 2020 by the authors. Licensee MDPI, Basel, Switzerland. This article is an open access article distributed under the terms and conditions of the Creative Commons Attribution (CC BY) license (http://creativecommons.org/licenses/by/4.0/).
Share and Cite
Meretoudi, A.; Banti, C.N.; Siafarika, P.; Kalampounias, A.G.; Hadjikakou, S.K. Tetracycline Water Soluble Formulations with Enhanced Antimicrobial Activity. Antibiotics 2020, 9, 845. https://doi.org/10.3390/antibiotics9120845
Meretoudi A, Banti CN, Siafarika P, Kalampounias AG, Hadjikakou SK. Tetracycline Water Soluble Formulations with Enhanced Antimicrobial Activity. Antibiotics. 2020; 9(12):845. https://doi.org/10.3390/antibiotics9120845
Chicago/Turabian StyleMeretoudi, A., C. N. Banti, P. Siafarika, A. G. Kalampounias, and S. K. Hadjikakou. 2020. "Tetracycline Water Soluble Formulations with Enhanced Antimicrobial Activity" Antibiotics 9, no. 12: 845. https://doi.org/10.3390/antibiotics9120845
APA StyleMeretoudi, A., Banti, C. N., Siafarika, P., Kalampounias, A. G., & Hadjikakou, S. K. (2020). Tetracycline Water Soluble Formulations with Enhanced Antimicrobial Activity. Antibiotics, 9(12), 845. https://doi.org/10.3390/antibiotics9120845





